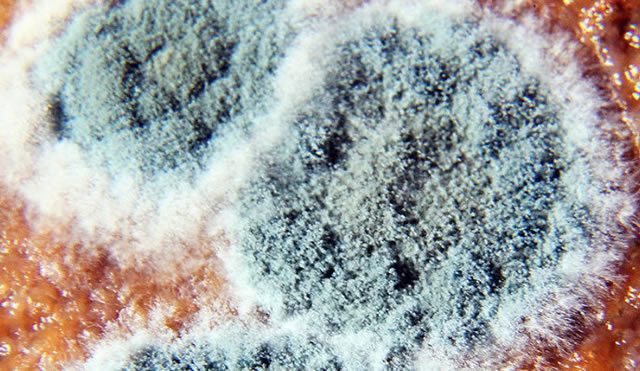

10 признаков того, что у вас отравление токсичной плесенью!
Плесень очень распространена и представляет собой огромную проблему в каждом доме, поскольку она растет повсеместно и приводит к многочисленным осложнениям со здоровьем.

Плесень часто появляется под раковиной, в подвале, в душевой занавеске, в углах, в гипсокартоне, и т. д.
Плесень может иметь 1000 видов, которые эксперты классифицируют в соответствии с их воздействием на людей и другие живые существа следующим образом:
Аллергенная:
Эта плесень является наименее опасным видом, и к ней более склонны дети. Она усугубляет симптомы астмы и приводит к проблемам у людей с предрасположенностью к аллергии к конкретной плесени.
Патогенная:
Патогенная плесень приводит к инфекциям и чрезвычайно опасна в случае слабой иммунной системы. У людей, подвергшихся воздействию этого вида плесени, развивается что-то подобное бактериальной пневмонии.
Токсигенная:
Этот вид плесени производит микотоксины, которые приводят к серьезным последствиям для здоровья, таким как иммуносупрессия и рак. Ядовитые химикаты в этом виде плесени поглощаются, как только они вдыхаются или попадают внутрь.
Хотя аллергия на плесень является наиболее распространенной проблемой, вызванной воздействием плесени, плесень может вызвать болезнь без аллергической реакции. Плесень также может вызывать инфекции или раздражающие и токсические реакции. Инфекции, вызванные плесенью, могут привести к множеству проблем от гриппоподобных симптомов к кожным инфекциям и даже пневмонии.
Токсичность плесени считается синдромом хронического воспалительного ответа и представляет собой еще одну серьезную проблему для здоровья.
Вот 10 наиболее распространенных симптомов болезни плесени:
• Глазные проблемы, такие как красные глаза или светочувствительность
• Головокружение
• Регулирование температуры или ночные поты
• Слабость и усталость
• Чрезмерная жажда и повышенное мочеиспускание
• Головные болиЗатуманенный мозг, проблемы с памятью
• Чувство покалывания и онемение
• Необъяснимые мышечные судороги и боль, боль в суставах
• Проблемы с астмой и синусом, такие как кашель или одышка дыхания
Пищеварительные проблемы, такие как диарея, тошнота, потеря аппетита, боль в животе
Плесень часто появляется под раковиной, в подвале, в душевой занавеске, в углах, в гипсокартоне, и т. д.
Плесень может иметь 1000 видов, которые эксперты классифицируют в соответствии с их воздействием на людей и другие живые существа следующим образом:
Аллергенная:
Эта плесень является наименее опасным видом, и к ней более склонны дети. Она усугубляет симптомы астмы и приводит к проблемам у людей с предрасположенностью к аллергии к конкретной плесени.
Патогенная:
Патогенная плесень приводит к инфекциям и чрезвычайно опасна в случае слабой иммунной системы. У людей, подвергшихся воздействию этого вида плесени, развивается что-то подобное бактериальной пневмонии.
Токсигенная:
Этот вид плесени производит микотоксины, которые приводят к серьезным последствиям для здоровья, таким как иммуносупрессия и рак. Ядовитые химикаты в этом виде плесени поглощаются, как только они вдыхаются или попадают внутрь.
Хотя аллергия на плесень является наиболее распространенной проблемой, вызванной воздействием плесени, плесень может вызвать болезнь без аллергической реакции. Плесень также может вызывать инфекции или раздражающие и токсические реакции. Инфекции, вызванные плесенью, могут привести к множеству проблем от гриппоподобных симптомов к кожным инфекциям и даже пневмонии.
Токсичность плесени считается синдромом хронического воспалительного ответа и представляет собой еще одну серьезную проблему для здоровья.
Вот 10 наиболее распространенных симптомов болезни плесени:
• Глазные проблемы, такие как красные глаза или светочувствительность
• Головокружение
• Регулирование температуры или ночные поты
• Слабость и усталость
• Чрезмерная жажда и повышенное мочеиспускание
• Головные болиЗатуманенный мозг, проблемы с памятью
• Чувство покалывания и онемение
• Необъяснимые мышечные судороги и боль, боль в суставах
• Проблемы с астмой и синусом, такие как кашель или одышка дыхания
Пищеварительные проблемы, такие как диарея, тошнота, потеря аппетита, боль в животе
Только зарегистрированные и авторизованные пользователи могут оставлять комментарии.
0
А как лечиться? Или избавиться?
- ↓
+1
Спасибо за интересные, полезные и ценные советы, воспользуюсь!
- ↓
+1
спасибо за информацию
- ↓
+6
Ну вот, по симптомам еще и плесенью траванулся. Что за дела — про любую болезнь читаю и всегда все совпадает (кроме гинекологии).
- ↓
+2
Это как «болезнь 3-го курса» в медине-изучают внутренние болезни и находят у себя чуть ли не все)))))
- ↑
- ↓

